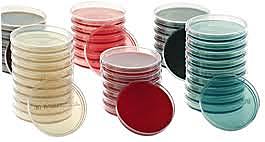
Método de cultivos enriquecidos

-
• Fue en 1590 los fabricantes holandeses de anteojos, Hans Janssen y su hijo Zacharias Janssen inventaron un microscopio compuesto colocando juntas dos lentes en un tubo.
-
Robert Hooke fisico naturalista publica miembro de la Royal society de londres, publica primer libro que se dedica a describir las observaciones hechas con el microscopio: micrographia.
-
Anton van Leeuwenh El primer hombre que observo bacterias
-
Nadie imaginaba que los gusanos eran en realidad los hijos de las moscas. Sin embargo Redi sospechó que así era y se dedicó a probarlo. Utilizando el método científico planteó su experimento.
-
los microorganismos sobrevivían y se desarrollaban aunque los frascos estuvieran herméticamente cerrados.encontró que si hervía los frascos parcialmente cerrados durante 45 minutos, el contenido se mantenía sin contaminarse casi indefinidamente, si se permitía la entrada de aire, el contenido entraba en putrefacción rápidamente, al hervir el contenido, el aire del frasco se hacía inadecuado para la existencia de vida en su interior y era interpretado como la ausencia de "fuerza vital"
-
El primer reporte de caso definitivo data de 1779 y es atribuido a Benjamin Rush, quien acuña el término «fiebre rompehuesos» por los síntomas de mialgias y artralgias.[4] En 1906, la transmisión por el mosquito Aedes fue confirmada, y en 1907 el dengue era la segunda enfermedad (después de la fiebre amarilla) que se conocía, que era producida por un virus
-
Fue de los primeros en estudiar microorganismos
-
Edward jenner un medico, investigador y poeta descubridor de la vacuna antivariólica que fue exitosa para combatir la peste que se presentaba en ese tiempo
-
Teoría germinal de las enfermedades infecciosas, que decía que cualquier enfermedad infecciosa la producía un germen que no procedía del desequilibrio de humores interiores, como mantenía medicina antigua. El germen infeccioso provenía del exterior del organismo y tenía la capacidad de poder expenderse entre las personas
-
En 1835 Agostino Bassi (1773-1856) demostró que cierta enfermedad del gusano de seda (mal di segno), que había hecho su aparición en Lombardía, se debía a un hongo (Botrytis bassiana)
-
trabajo experimental con microorganismos ha de tener en cuenta los factores ambientales, es decir, una serie de agentes físicos y químicos que detengan el crecimiento de las bacterias
-
todos los seres vivos están compuestos por células y por productos elaborados por ellas
-
1838: Charles Cagniard-Latour, memoria sobre la fermentación alcohólica.
-
En 1840 Henle, de la escuela fisiológica de Johannes Müller, planteó la teoría de que las enfermedades infecciosas están causadas por seres vivos invisibles, pero de nuevo la confirmación de estas ideas tuvo que esperar a que la intervención de Pasteur demostrara la existencia de microorganismos específicos responsables de enfermedades.
-
Miles Joseph Berkeley descubre un hongo (Phytophthira infestans) que produce la pobredumbre de la patata.
-
Demostró que el cólera era producido por el consumo de aguas contaminados con partículas de material defecado en lugares donde el agua era consumida esta estaba contaminada por heces en la ciudad de Londres
-
Ignaz Semmelweis, fue un obstetra húngaro que a mediados del siglo XIX, precediendo los hallazgos de Pasteur y Lister, logró descubrir la naturaleza infecciosa de la fiebre puerperal, logrando controlar su aparición con una simple medida de antisepsia.
-
El ántrax es una enfermedad infecciosa aguda causada por una bacteria grampositiva que se llama Bacillus anthracis que forma esporas. El ántrax ocurre con mayor frecuencia en los vertebrados menores, silvestres y domésticos, pero también puede ocurrir en seres humanos cuando tienen contacto con los animales infectados o el tejido de animales infectados.
-
1857-1861: Louis Pasteur realiza una serie de experimentos que demuestran el origen microbio de procesos de fermentación láctica, alcohólica, existencia de microorganismos anaerobios y demuestra que sólo puede producirse crecimiento microbio a partir de microorganismos preexistentes.
-
John snow condujo a nuevas ideas tan importantes como el desarrollo de vacunas los antibióticos la esterializacion y la higiene como métodos efectivos de cura y prevención contra enfermedades
-
Lister estaba al corriente de las ideas de Pasteur. (demostro que las putrefacciones se debían a la llegada de gérmenes vivos hasta la materia putrefascible,Probó el cloruro de cinc y los sulfitos, pero pensó que podía emplear el ácido fénico, sustancia que se obtenía facilmente del alquitrán de hulla y que, desde 1859, se venía empleando para evitar putrefacciones.estudio Un farmacéutico parisino apellidado Lemaire, microorganismos no se desarrollaban en su presencia.
-
Pasteur, Tyndall y Appert contribuyeron al establecimiento de la esterilización como una de las técnicas fundamentales para la microbiología.
-
Aisla bacterias fijadoras de nitrogeno de los nodulos presentes en las raices de leuminosas.
-
1881: Louis Pasteur desarrolla vacunas frente a varias enfermedades víricas.
-
1881 - Carlos Finlay observa que la fiebre amarilla es transmitida por mosquitos
-
Descubrió el bacilo de la tuberculosis, que fue denominado "bacilo de Koch" es una bacteria que causa la tuberculosis en los seres humanos
-
1884: Robert Koch realiza varios estudios sobre los agentes causantes de diversas enfermedades infecciosas.
-
ara la realización de una tinción de gram se utilizan dos colorantes. Uno de carácter primario, como es el cristal violeta, y otro de contraste, como la safranina. También se utiliza un mordiente para la safranina, como es el lugol, y un decolorante como el alcohol/acetona.
Esta tinción pone de manifiesto la afinidad tintorial de la pared, la cual depende de su composición para que el microorganismo sea considerado gram+ o gram- -
1885 - Louis Pasteur puso a punto una vacuna contra la rabia
La rabia es una enfermedad aguda infecciosa viral del sistema nervioso central ocasionada por un Rhabdoviridae que causa encefalitis aguda con una letalidad cercana al 100 %. Es la zoonosis viral conocida más antigua. -
En 1886 Escherich descubre Escherichia coli.
Escherichia coli descrita por primera vez en 1885 por Theodore Von Escherich, quien la denominó Bacterium coli.commune dado que se aislaba de las heces de individuos sanos y enfermos. Forma parte de los microorganismos que colonizan el intestino por lo que se define como un comensal que integra la biota intestinal de diferentes mamíferos incluido el hombre. -
Maximus. V. Beijerinck descubre las bacterias que modulan las leguminosas
-
S. Winogradsky realiza los primeros estudios sobre los producidos por bacterias.
-
En 1890 Emil Adolf von Behringdescubrió la antitoxina del tétanos junto con el bacteriólogo japonés Shibasaburo Kitasato. Descubrieron que al inyectar el suero sanguíneo de un animal afectado por el tétanos a otro, se genera inmunidad a la enfermedad en el segundo. Comprobaron que los animales inmunizados contra el tétanos presentaban esta cualidad porque debían disponer de alguna sustancia capaz de controlar la infección.
-
Gracias a sus estudio fue el responsable del aislamiento y descripción por vez primera tanto de las bacterias nitrificantes como de las fijadoras de nitrógeno (ciclo del nitrógeno).
-
Dimitri Ivanovski demuestra que el mosaico del tabaco es producido por un virus
.investigó una enfermedad que afectaba el tabaco –se manifestaba por la formación de un diseño en forma de mosaico sobre las hojas– que denominó contagium vivum fluidum -
1898: Friedrich Loeffler y F. Frosch describen el agente causante de la glosopeda (: aislamiento de virus animales
-
Fue descubierto por Martinus Beijerinck en 1901. Es un medio de cultivo que contiene los nutrientes necesarios para apoyar el crecimiento de una amplia variedad de microorganismos, entre ellos algunos de los más exigentes. Se utilizan comúnmente para la cosecha de diferentes tipos de microbios que están presentes en la muestra.
-
Howard taylor R. demuestra q ue la fiebre de laa montañas rocosas es trasmitida por las garrapatas y aislo al microorganismo causante de la enfermedad, que el llamo rickettsia. fallecio por esta enfermedad
-
1917: F. d'Herelle descubre el primer virus bacteriano (bacteriofago).
-
En las bacterias virulentas S muertas había “algo” capaz de
transformar a las bacterias R,inocuas, en bacterias virulentas S. Ese “algo”, llamado por Griffith “factor transformante”, tenía información para producir un carácter heredable en las bacterias R, que era la presencia de la cápsula (responsable de la virulencia). Se trataba, por lo tanto del material genético. -
El descubrimiento de la penicilina, una de las más importantes adquisiciones de la terapéutica moderna, tuvo su origen en una observación fortuita. En septiembre de 1928, Fleming, durante un estudio sobre las mutaciones de determinadas colonias de estafilococos, comprobó que uno de los cultivos había sido accidentalmente contaminado por un microorganismo procedente del aire exterior, un hongo posteriormente identificado como el Penicillium notatum.
-
En 1931 fue mostrado que ese virus de la gripe podría cultivarse en huevos de pollo fertilizados, un método que todavía se utiliza hoy para producir vacunas. dado que no compremete la vida humada y es una condicion de engrendacion controlable
-
helmun ruska, inventa el microscopio electronico
-
El primer indicio de que un virus carcinógeno lo tuvo el biólogo americano John Bittner en 1936, quien descubrió que el cáncer de mama del ratón era debido a un retrovirus, el MMTV (virus del tumor mamario del ratón). Aunque se ha buscado algún agente vírico responsable del cáncer de mama humano, no se ha llegado a ningún resultado concluyente
-
En 1943, Jacob Light y Horace Hodes demostraron que un agente filtrable en las heces de los niños con diarrea infecciosa también causaba diarrea en el ganado.En 1973, Ruth Bishop y sus compañeros describieron el virus relacionado con la gastroenteritis infantil.En 1974, Thomas Henry Flewett sugirió el nombre de rotavirus tras observarlo por el microscopio electrónico, dónde vio que parecía una rueda, 1943 el nombre fue oficialmente reconocido por el Comité Internacional de Taxonom
-
Este virus se detectó por primera vez en Tanzania en 1952,y fue descrito por W. H. R. Lumsden, uno de los colaboradores del equipo del epidemiólogo Marion Robinson
-
El virus Epstein-Barr fue documentado por primera vez en 1964, pero no se descubrió que fuera un virus de herpes hasta 1968. El virus humano del herpes 3 fue documentado por primera vez por J. Ramsay Hunt en 1907.
-
Es una enfermedad vírica aguda grave que se suele caracterizar por la aparición súbita de fiebre, debilidad intensa y dolores musculares, de cabeza y de garganta, lo cual va seguido de vómitos, diarrea, erupciones cutáneas, disfunción renal y hepática y, en algunos casos, hemorragias internas y externas. El virus, enfermedad homónima (antes conocida como fiebre hemorrágica del Ébola)
-
1983 Luc Montagnier descubre el agente causante: el VIH (virus de inmunodeficiencia humana)
Es un virus que destruye determinadas células del sistema inmunitario (la defensa del cuerpo contra las enfermedades que nos ayuda a mantenernos sanos). Cuando el VIH daña el sistema inmunitario, es más fácil que te enfermes de gravedad e incluso que mueras a causa de infecciones que el cuerpo normalmente podría combatir.. -
se encuentra el genoma del hongo Saccharomyces cerevisiae.
-
se descubre la bacteria gigante Thiomargarita namibiensis, es una proteobacteria gram-negativa, Es la bacteria más grande conocida, con una longitud de hasta 750 μm (0,75 mm),[1] lo que la hace visible a simple vista.
-
Heidelberg y col. descubre que Vibrio cholerae tiene dos cromosoms circulares
-
hopwood y col. realizaron la secuencia del genoma streptomyces coliecolor
-
aparece en Asia la gripe aviar, producida por el subtipo H5N1 del virus Influenza A que puede transmitirse al hombre.
-
El género Mycobacterium caracterizado por ser bacilos ácido alcohol resistentes, aerobios de crecimiento lento, con alto contenido de G-C, comprende numerosas especies entre ellas el agente etiológico de la tuberculosis en el humano y animales, la lepra y un grupo muy numeroso de especies, algunas potencialmente patógenas y otras saprofitas (Kazda et al.,2009).
-
se inicio la ultima fase para la erradicación mundial de la infección natural polio.
es una enfermedad infecciosa, también llamada de forma abreviada polio, que afecta principalmente al sistema nervioso, La enfermedad la produce el virus poliovirus -
se secuencia el genoma de la bacteria Haemophilus influenzae
A list shows items. A timeline shows sequence.
Use Timetoast to make dates, milestones, and turning points easier to understand in a clear visual format. Timetoast is a timeline maker for work, school, research, and stories.